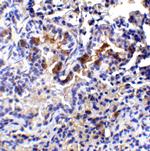
TM4SF1 Antibody in Immunohistochemistry (IHC)

Search
Invitrogen
TM4SF1 Polyclonal Antibody
{{$productOrderCtrl.translations['antibody.pdp.commerceCard.promotion.promotions']}}
{{$productOrderCtrl.translations['antibody.pdp.commerceCard.promotion.viewpromo']}}
{{$productOrderCtrl.translations['antibody.pdp.commerceCard.promotion.promocode']}}: {{promo.promoCode}} {{promo.promoTitle}} {{promo.promoDescription}}. {{$productOrderCtrl.translations['antibody.pdp.commerceCard.promotion.learnmore']}}

Please note: We are reviewing Western blot images included in the antibody testing data in our catalog, including those provided by third parties. Unless expressly labeled or annotated as “raw-unedited”, Western blot images included in the antibody testing data in our catalog may have been edited, optimized or otherwise adjusted for presentation.
产品信息
PA5-21119
种属反应
已发表种属
宿主/亚型
分类
类型
抗原
偶联物
形式
浓度
规格
纯化类型
保存液
内含物
保存条件
运输条件
RRID
产品详细信息
A suggested positive control is human lung tissue lysate.
PA5-21119 can be used with blocking peptide PEP-1233.
靶标信息
TM4SF1 is a member of the transmembrane 4 superfamily, also known as the tetraspanin family. Most of these members are cell-surface proteins that are characterized by the presence of four hydrophobic domains and mediate signal transduction events that play a role in the regulation of cell development, activation, growth and motility. TM4SF1 is a cell surface antigen and is highly expressed in the vascular endothelium of several human cancers. Knockdown experiments of TM4SF1 prevented filopodia formation, inhibited cell mobility, blocked cytokinesis, and inhibited maturation of VEGF-A-induced angiogenesis, suggesting that TM4SF1 may be an attractive target for anti-angiogenesis therapy.
仅用于科研。不用于诊断过程。未经明确授权不得转售。
生物信息学
蛋白别名: 12A8 target antigen; L6 antigen; Membrane component chromosome 3 surface marker 1 homolog; membrane component, surface marker 1; Transmembrane 4 L6 family member 1; transmembrane 4 superfamily member 1; Tumor-associated antigen L6
基因别名: L6; M3s1; Tm4sf1
UniProt ID: (Mouse) Q64302
Entrez Gene ID: (Mouse) 17112, (Rat) 295061




